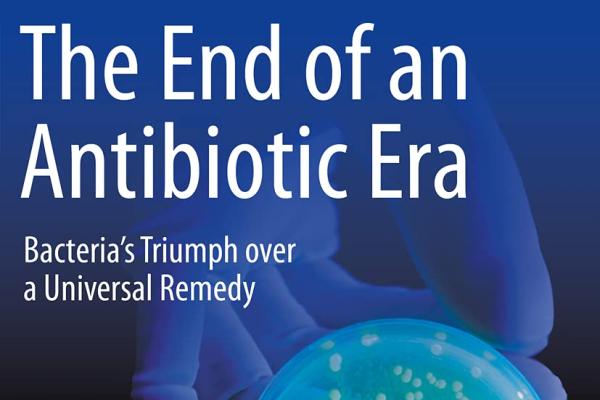

Amazigh is an undercover report about the hirak, the popular movement in the disadvantaged Rif area, and tells the story of those who left, stayed or were arrested.
We meet Mohammed, who is living illegally in Antwerp. Together with his best friend Nasser Zefzafi, he went through the streets of Al Hoceima to stand up for his rights. His friend was arrested, he himself fled. In Al Hoceima, we meet the parents of protest leader Nasser Zefzafi, Nasser El Ouazizi - frontman of the band Agraf, a teacher, a hairdresser and a self-employed person.
You can read more about the story behind Amazigh here (in Dutch)
One of the creators of the report wishes to remain anonymous for security reasons.
Photo: © Evelyne Dierickx & Manon Duerinck